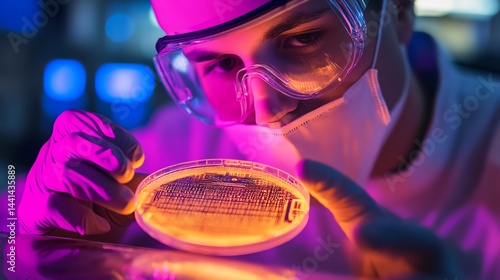

Employees are developing exposed wafers using chemical solutions to reveal circuit patterns.
Dobierz idealny dla Ciebie rozmiar i zamów ten obraz na Twoją ściane. Na drukowanych obrazach nie występuje znak wodny "Adobe Stock" oraz numer wzoru.
Rozmiar wydruku
Szerokość: {{ imgW }}cm
Wysokość: {{ imgH }}cm
Szerokość
Wysokość
Specyfikacja wydruku
Materiał
Grubość ramy
Sposób zadrukowania boków
Chcesz dodać dedykacje?
Suma: {{ price }} zł
{{ netPrice }}zł netto
Cena brutto bez rabatu {{ clientRabat }}%: {{ priceWoRabat }}zł
Twoje przesłane zdjęcia:
Plik jest zbyt niskiej rozdzielczości, żeby wykorzystać go do wydruku, prześlij inne zdjęcie (minimum {{ tooSmallImageWarning }}) lub kliknij i dowiedz się więcej.
Produkt dodany do koszyka
{{ imgW }}x{{ imgH }} cm

Obraz drukowany na płótnie - Employees are developing exposed wafers using chemical solutions to reveal circuit patterns.
Cena za obraz 105x55 cm - 203,25 zł
specyfikacja: Employees are developing exposed wafers using chemical solutions to reveal circuit patterns.
-
Typ produktuObraz drukowany na płótnie
-
NazwaEmployees are developing exposed wafers using chemical solutions to reveal circuit patterns.
-
Płótno:Canvas 380g
-
DrukAtramentowy
-
DrukarkaEpson SC S80610
-
AtramentyEpson Ultrachrome GS3
-
Dostępnośćna stanie
-
CenaObraz 105x55 cm - 203,25 zł
-
ZastosowanieDekoracje domowe, przestrzenie komercyjne, biura, hotele
-
WykończenieNaciągnięcie na ramę, gotowy do zawieszenia
-
Gwarancja24 miesiące
-
ProducentGaleriaDruku
-
Opis
Wideo Prezentacja produktów
Tak może prezentować się Twój obraz.
Sprawdź wizualizacje dla obrazu Employees are developing exposed wafers using chemical solutions to reveal circuit patterns. drukowanym na płótnie. Przedstawiamy kilka wizualizacji wydruku w różej aranżacji oraz kolortyce ścian. Wizualizacje uwzględniają wydruk całego pliku, dokładny kadr i rozmiar możesz wybrać podczas konfigurowania obrazu na górze strony.
Na drukowanych obrazach nie występuje znak wodny "Adobe Stock" oraz numer wzoru.

Więcej z tej serii
Jeśli interesuje Cię to zdjęcie, zobacz więcej z tej serii.